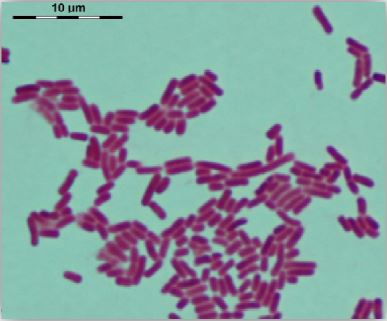
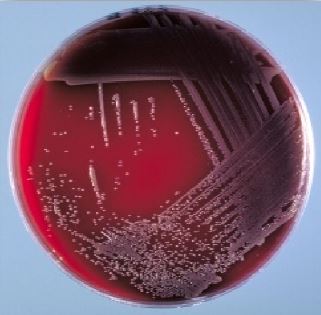
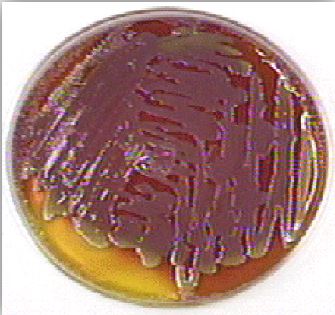
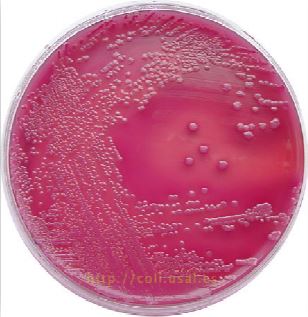
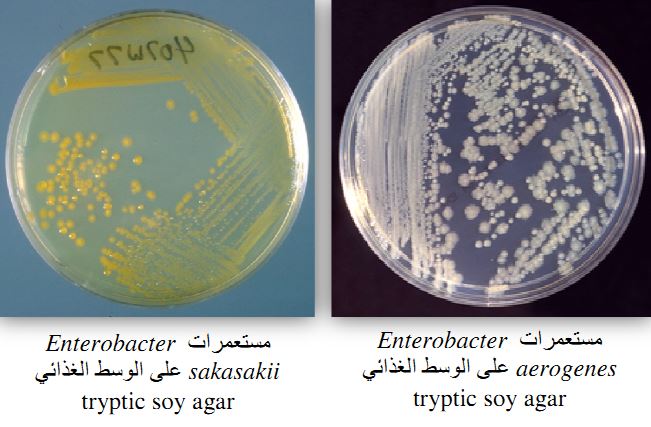
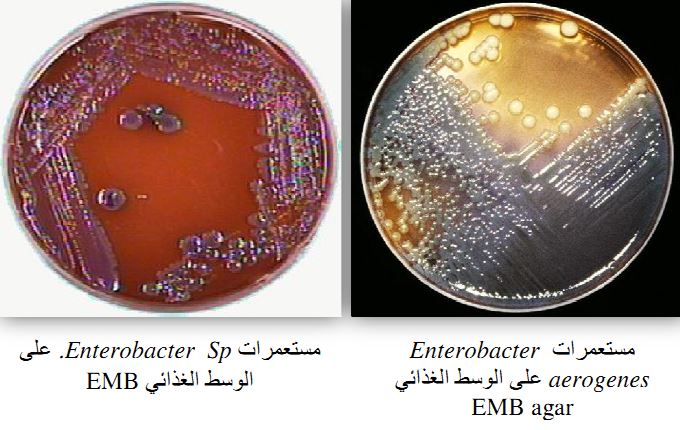

النبات

مواضيع عامة في علم النبات

الجذور - السيقان - الأوراق

النباتات الوعائية واللاوعائية

البذور (مغطاة البذور - عاريات البذور)

الطحالب

النباتات الطبية


الحيوان

مواضيع عامة في علم الحيوان

علم التشريح

التنوع الإحيائي

البايلوجيا الخلوية


الأحياء المجهرية

البكتيريا

الفطريات

الطفيليات

الفايروسات


علم الأمراض

الاورام

الامراض الوراثية

الامراض المناعية

الامراض المدارية

اضطرابات الدورة الدموية

مواضيع عامة في علم الامراض

الحشرات


التقانة الإحيائية

مواضيع عامة في التقانة الإحيائية


التقنية الحيوية المكروبية

التقنية الحيوية والميكروبات

الفعاليات الحيوية

وراثة الاحياء المجهرية

تصنيف الاحياء المجهرية

الاحياء المجهرية في الطبيعة

أيض الاجهاد

التقنية الحيوية والبيئة

التقنية الحيوية والطب

التقنية الحيوية والزراعة

التقنية الحيوية والصناعة

التقنية الحيوية والطاقة

البحار والطحالب الصغيرة

عزل البروتين

هندسة الجينات


التقنية الحياتية النانوية

مفاهيم التقنية الحيوية النانوية

التراكيب النانوية والمجاهر المستخدمة في رؤيتها

تصنيع وتخليق المواد النانوية

تطبيقات التقنية النانوية والحيوية النانوية

الرقائق والمتحسسات الحيوية

المصفوفات المجهرية وحاسوب الدنا

اللقاحات

البيئة والتلوث


علم الأجنة

اعضاء التكاثر وتشكل الاعراس

الاخصاب

التشطر

العصيبة وتشكل الجسيدات

تشكل اللواحق الجنينية

تكون المعيدة وظهور الطبقات الجنينية

مقدمة لعلم الاجنة


الأحياء الجزيئي

مواضيع عامة في الاحياء الجزيئي


علم وظائف الأعضاء


الغدد

مواضيع عامة في الغدد

الغدد الصم و هرموناتها

الجسم تحت السريري

الغدة النخامية

الغدة الكظرية

الغدة التناسلية

الغدة الدرقية والجار الدرقية

الغدة البنكرياسية

الغدة الصنوبرية

مواضيع عامة في علم وظائف الاعضاء

الخلية الحيوانية

الجهاز العصبي

أعضاء الحس

الجهاز العضلي

السوائل الجسمية

الجهاز الدوري والليمف

الجهاز التنفسي

الجهاز الهضمي

الجهاز البولي


المضادات الميكروبية

مواضيع عامة في المضادات الميكروبية

مضادات البكتيريا

مضادات الفطريات

مضادات الطفيليات

مضادات الفايروسات

علم الخلية

الوراثة

الأحياء العامة

المناعة

التحليلات المرضية

الكيمياء الحيوية

مواضيع متنوعة أخرى

الانزيمات
الجنس Enterobacter Spp
المؤلف:
عبد الرزاق سليمان التومي ، محمد محمد الامام ، عبد الباسط رمضان
المصدر:
اساسيات التشخيص البكتريولوجي المعملي والسريري
الجزء والصفحة:
11-7-2016
11732
Enterobacter Spp
خلايا هذا الجنس البكتيري عصوية الشكل وهي سالبة لصبغة جرام، اختيارية التهوية ومتحركة ، ويمكن أن تكون حافظة صغيرة حجم وتتواجد بصورة شائعة في القناة الهظمية للإنسان والحيوان وفي التربة ومياه الصرف الصحي ومنتجات الألبان .
Enterobacter cloacae
الامراضية :
يضم هذا الجنس البكتيري العديد من الأنواع البكتيرية الممرضة التي تسبب الامراض الانتهازية خاصة للأشخاص الذين يعانون من خلل في الجهاز المناعي والأشخاص الذين يستعينون بأجهزة خارجية مثل جهاز التنفس الصناعي mechanical ventilation كما يسبب التهاب المسالك البولية والتهاب الجروح وتجرثم الدم وهو المسئول عن العديد من حالات عدوى المستشفيات . ومن هذه الأنواع البكتيرية نجد النوع البكتيري Enterobacter cloacae والنوع البكتيري E. aerogens والنوع البكتيري E. gergoviae والنوع البكتيري E. sakasakii والذي أصبح يصنف على أنه Cronobacter Spp. .
التشخيص المعملي :
ــ الوسط الغذائي Blood agar : تكون مستعمرات هذا الجنس البكتيري كبيرة الحجم وتشبه إلى حد كبير مستعمرات الجنس البكتيري Klebsiella Spp إلا أنها أقل لزوجة.
مستعمرات Enterobacter sakasakii على الوسط الغذائي Blood agar
ــ الوسط الغذائي XLD agar : المستعمرات البكتيرية النامية يكون لونها أصفر نتيجة لقدرة هذا الجنس البكتيري على تخمير سكر اللاكتوز وسكر السكروز ، كما له القدرة على تكسير الحمض الأميني lysine مما يؤدي لتحول لون الوسط الغذائي إلى اللون الأحمر الغامق مع عدم تكون كبريتيد الهيدروجين.
مستعمرات Enterobacter aerogenes على الوسط الغذائي XLD agar
ــ الوسط الغذائي MacConkey agar : المستعمرات البكتيرية النامية تكون لزجة القوام وكبيرة الحجم وبلون أحمر نتيجة لقدرتها على تخمير سكر اللاكتوز.
مستعمرات Enterobacter aerogenes على الوسط الغذائي MacConkey agar
ــ الوسط الغذائي Tryptic soya agar
ــ الوسط الغذائي EMB agar : المستعمرات البكتيرية النامية تكون لزجة القوام وكبيرة الحجم ، وبلون يتراوح من اللون الوردي إلى البنفسجي نتيجة لتخميرها لسكر اللاكتوز ، ولكنها لا تكون الغشاء الأخضر اللماع green methalic sheen مثل النوع البكتيري E. coli.
الاختبارات المعملية :
ــ اختبار الكشف على الاندول : سالب.
ــ اختبار الكشف على السيترات : موجب.
ــ اختبار الكشف على إنزيم urease : سالب.
الاكثر قراءة في البكتيريا
اخر الاخبار
اخبار العتبة العباسية المقدسة
الآخبار الصحية

قسم الشؤون الفكرية يصدر كتاباً يوثق تاريخ السدانة في العتبة العباسية المقدسة
"المهمة".. إصدار قصصي يوثّق القصص الفائزة في مسابقة فتوى الدفاع المقدسة للقصة القصيرة
(نوافذ).. إصدار أدبي يوثق القصص الفائزة في مسابقة الإمام العسكري (عليه السلام)